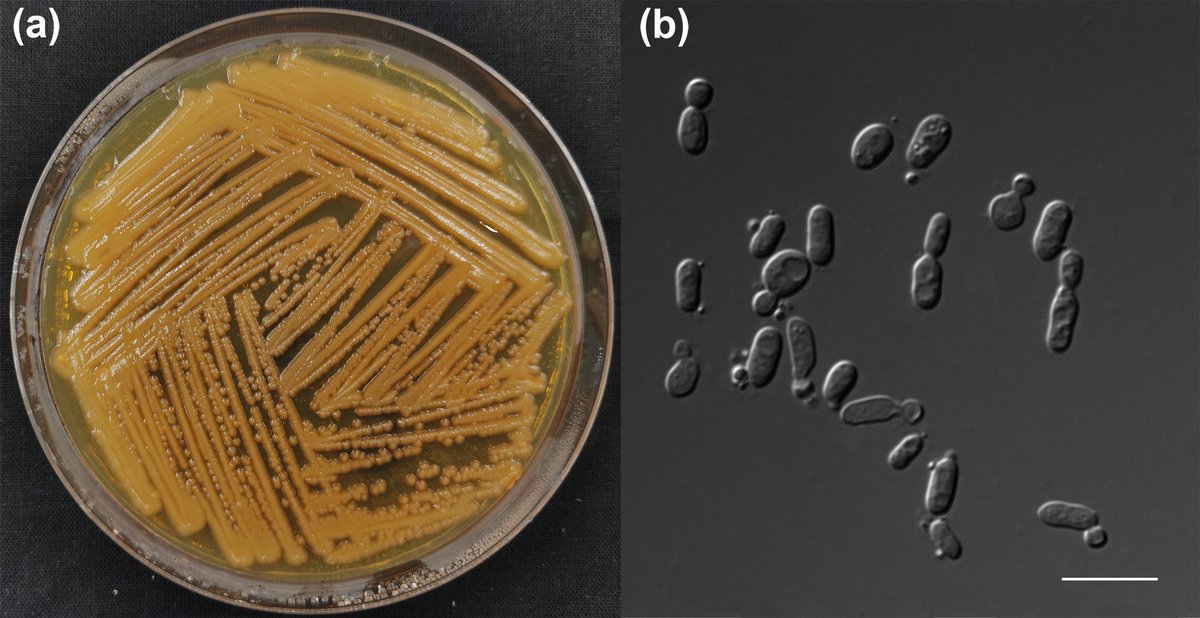
MicrobioSoc's tweet image. Rhodotorula silvicola sp. nov., a new yeast species from plant-associated substrates and mushroom. Published Open Access and fee-free in IJSEM using a Publish and Read agreement: doi.org/10.1099/ijsem.… #IJSEM #PublishAndRead

#ijsem search results
Aureibaculum koreense sp. nov. and Aureibaculum conchae sp. nov., isolated from the marine molluscs. Available to read in IJSEM: doi.org/10.1099/ijsem.… #IJSEM

Comparative genomics and ecological insights into Nonomuraea turcica sp. nov., an actinomycete from Black Sea island soil. Read now in IJSEM: doi.org/10.1099/ijsem.… #IJSEM

Solicola agrisoli sp. nov., a novel actinobacterium isolated from agricultural soil in Republic of South Korea. Read more about this in IJSEM: doi.org/10.1099/ijsem.… #IJSEM

Streptomyces mayonensis sp. nov., isolated from the volcanic soils of Mt. Mayon, Philippines. Published in IJSEM: doi.org/10.1099/ijsem.… #IJSEM

Cyberlindnera hibernica sp. nov. and Barnettozyma discipulorum sp. nov., isolated from forest soil in Ireland. Published Open Access and fee-free in IJSEM using a Publish and Read agreement: #IJSEM #PublishAnd Read doi.org/10.1099/ijsem.…

Diverse biofilm-forming Sphingomonadaceae represent twelve novel species isolated from glaciers on the Tibetan Plateau. Published Open Access and fee-free in IJSEM using a Publish and Read agreement: doi.org/10.1099/ijsem.… #IJSEM #PublishAndRead

Leveraging the subgenus category to address monophyletic genus over-splitting: illustration with recently proposed Mycobacteriales genera. Published Open Access and fee-free in IJSEM using a Publish and Read agreement: doi.org/10.1099/ijsem.… #IJSEM #PublishAndRead

A fish out of water? Researchers at the University of Hawai'i Manoa identify a novel species of Caulobacter bacteria from a seawater sample that is unable to survive the salty conditions, in a new paper published in #IJSEM
EzBioCloud: a genome-driven database and platform for microbiome identification and discovery #OpenAccess in @MicrobioSoc #IJSEM doi.org/10.1099/ijsem.…

Extremely valuable getting together clinical microbiologists, taxonomists and all sorts of other researchers to build consensus on questions of bacterial nomenclature at @MicrobioSoc #FitForPurpose2023 in Strathclyde #IJSEM

Rhodotorula silvicola sp. nov., a new yeast species from plant-associated substrates and mushroom. Published Open Access and fee-free in IJSEM using a Publish and Read agreement: doi.org/10.1099/ijsem.… #IJSEM #PublishAndRead

A description of a new species belonging to the genus Hannaella is on the current issue of #IJSEM . This paper results as a collaboration between PYCC and @YGL_NOVAFCT . A special thanks to everyone involved 😊🌷🧫🔬

Knoellia altitudinis sp. nov., Knoellia pratensis sp. nov., Knoellia terrae sp. nov. and Knoellia tibetensis sp. nov., four novel UV radiation-resistant actinobacteria isolated from Tibet Autonomous Region, China. Published in IJSEM: doi.org/10.1099/ijsem.… #IJSEM

Chlamydia vaughanii sp. nov., a novel Chlamydia isolated from a tropical fish (bushymouth catfish). See more in IJSEM: doi.org/10.1099/ijsem.… #IJSEM

Aestuariibius violaceus sp. nov., isolated from a marine limpet Cellana toreuma. Published Open Access and fee-free in IJSEM using a Publish and Read agreement: doi.org/10.1099/ijsem.… #IJSEM #PublishAndRead

Melissospora conviva gen. nov., sp. nov., a novel actinobacterial genus isolated from beehive through cross-feeding interactions. Published Open Access and fee-free in IJSEM using a Publish and Read agreement: doi.org/10.1099/ijsem.… #IJSEM #PublishAndRead

Fodinibius alkaliphilus sp. nov., a moderately halophilic and alkaliphilic bacterium isolated from an inland saltern in central Portugal and reclassification of Aliifodinibius salipaludis as Fodinibius salipaludis sp. nov. Discover more in IJSEM: doi.org/10.1099/ijsem.… #IJSEM

Pseudomonas lyxosi sp. nov., Pseudomonas arabinosi sp. nov. and Pseudomonas frigoris sp. nov., isolated from glaciers. Published #OpenAccess and fee-free in #IJSEM using a #PublishAndRead agreement: doi.org/10.1099/ijsem.…

Clostridium caseinilyticum sp. nov., a close relative of Clostridium tepidum and Clostridium sporogenes, isolated from spoiled cheese and silage. See more in IJSEM: doi.org/10.1099/ijsem.… #IJSEM

Aureibaculum koreense sp. nov. and Aureibaculum conchae sp. nov., isolated from the marine molluscs. Available to read in IJSEM: doi.org/10.1099/ijsem.… #IJSEM

Comparative genomics and ecological insights into Nonomuraea turcica sp. nov., an actinomycete from Black Sea island soil. Read now in IJSEM: doi.org/10.1099/ijsem.… #IJSEM

Solicola agrisoli sp. nov., a novel actinobacterium isolated from agricultural soil in Republic of South Korea. Read more about this in IJSEM: doi.org/10.1099/ijsem.… #IJSEM

Cyberlindnera hibernica sp. nov. and Barnettozyma discipulorum sp. nov., isolated from forest soil in Ireland. Published Open Access and fee-free in IJSEM using a Publish and Read agreement: #IJSEM #PublishAnd Read doi.org/10.1099/ijsem.…

Leveraging the subgenus category to address monophyletic genus over-splitting: illustration with recently proposed Mycobacteriales genera. Published Open Access and fee-free in IJSEM using a Publish and Read agreement: doi.org/10.1099/ijsem.… #IJSEM #PublishAndRead

A fish out of water? Researchers at the University of Hawai'i Manoa identify a novel species of Caulobacter bacteria from a seawater sample that is unable to survive the salty conditions, in a new paper published in #IJSEM
Diverse biofilm-forming Sphingomonadaceae represent twelve novel species isolated from glaciers on the Tibetan Plateau. Published Open Access and fee-free in IJSEM using a Publish and Read agreement: doi.org/10.1099/ijsem.… #IJSEM #PublishAndRead

Streptomyces mayonensis sp. nov., isolated from the volcanic soils of Mt. Mayon, Philippines. Published in IJSEM: doi.org/10.1099/ijsem.… #IJSEM

Clostridium caseinilyticum sp. nov., a close relative of Clostridium tepidum and Clostridium sporogenes, isolated from spoiled cheese and silage. See more in IJSEM: doi.org/10.1099/ijsem.… #IJSEM

Melissospora conviva gen. nov., sp. nov., a novel actinobacterial genus isolated from beehive through cross-feeding interactions. Published Open Access and fee-free in IJSEM using a Publish and Read agreement: doi.org/10.1099/ijsem.… #IJSEM #PublishAndRead

Knoellia altitudinis sp. nov., Knoellia pratensis sp. nov., Knoellia terrae sp. nov. and Knoellia tibetensis sp. nov., four novel UV radiation-resistant actinobacteria isolated from Tibet Autonomous Region, China. Published in IJSEM: doi.org/10.1099/ijsem.… #IJSEM

Rhodotorula silvicola sp. nov., a new yeast species from plant-associated substrates and mushroom. Published Open Access and fee-free in IJSEM using a Publish and Read agreement: doi.org/10.1099/ijsem.… #IJSEM #PublishAndRead

Aestuariibius violaceus sp. nov., isolated from a marine limpet Cellana toreuma. Published Open Access and fee-free in IJSEM using a Publish and Read agreement: doi.org/10.1099/ijsem.… #IJSEM #PublishAndRead

Fodinibius alkaliphilus sp. nov., a moderately halophilic and alkaliphilic bacterium isolated from an inland saltern in central Portugal and reclassification of Aliifodinibius salipaludis as Fodinibius salipaludis sp. nov. Discover more in IJSEM: doi.org/10.1099/ijsem.… #IJSEM

Fodinibius alkaliphilus sp. nov., a moderately halophilic and alkaliphilic bacterium isolated from an inland saltern in central Portugal and reclassification of Aliifodinibius salipaludis as Fodinibius salipaludis sp. nov. Discover more in IJSEM: doi.org/10.1099/ijsem.… #IJSEM

Chlamydia vaughanii sp. nov., a novel Chlamydia isolated from a tropical fish (bushymouth catfish). See more in IJSEM: doi.org/10.1099/ijsem.… #IJSEM

Pseudomonas lyxosi sp. nov., Pseudomonas arabinosi sp. nov. and Pseudomonas frigoris sp. nov., isolated from glaciers. Published #OpenAccess and fee-free in #IJSEM using a #PublishAndRead agreement: doi.org/10.1099/ijsem.…

Genome-based reclassification of the genus Lactococcus and two novel species Pseudolactococcus yaeyamensis gen. nov., sp. nov. and Lactovum odontotermitis sp. nov. isolated from the gut of termites. Published #OpenAccess and fee-free in #IJSEM using a #PublishAndRead agreement:

Streptomyces sediminimaris sp. nov., a novel actinobacterium with anticancer potential isolated from mangrove sediments. Find out more in #IJSEM: doi.org/10.1099/ijsem.…

Amycolatopsis ponsaeliensis sp. nov., a novel endophytic actinobacterium isolated from the root nodules of Alnus glutinosa. Published #OpenAccess and fee-free in #IJSEM using a #PublishAndRead agreement: doi.org/10.1099/ijsem.…

Comparative genomics and ecological insights into Nonomuraea turcica sp. nov., an actinomycete from Black Sea island soil. Read now in IJSEM: doi.org/10.1099/ijsem.… #IJSEM

Solicola agrisoli sp. nov., a novel actinobacterium isolated from agricultural soil in Republic of South Korea. Read more about this in IJSEM: doi.org/10.1099/ijsem.… #IJSEM

Aureibaculum koreense sp. nov. and Aureibaculum conchae sp. nov., isolated from the marine molluscs. Available to read in IJSEM: doi.org/10.1099/ijsem.… #IJSEM

Streptomyces mayonensis sp. nov., isolated from the volcanic soils of Mt. Mayon, Philippines. Published in IJSEM: doi.org/10.1099/ijsem.… #IJSEM

Cyberlindnera hibernica sp. nov. and Barnettozyma discipulorum sp. nov., isolated from forest soil in Ireland. Published Open Access and fee-free in IJSEM using a Publish and Read agreement: #IJSEM #PublishAnd Read doi.org/10.1099/ijsem.…

Leveraging the subgenus category to address monophyletic genus over-splitting: illustration with recently proposed Mycobacteriales genera. Published Open Access and fee-free in IJSEM using a Publish and Read agreement: doi.org/10.1099/ijsem.… #IJSEM #PublishAndRead

Diverse biofilm-forming Sphingomonadaceae represent twelve novel species isolated from glaciers on the Tibetan Plateau. Published Open Access and fee-free in IJSEM using a Publish and Read agreement: doi.org/10.1099/ijsem.… #IJSEM #PublishAndRead

EzBioCloud: a genome-driven database and platform for microbiome identification and discovery #OpenAccess in @MicrobioSoc #IJSEM doi.org/10.1099/ijsem.…

Extremely valuable getting together clinical microbiologists, taxonomists and all sorts of other researchers to build consensus on questions of bacterial nomenclature at @MicrobioSoc #FitForPurpose2023 in Strathclyde #IJSEM

Knoellia altitudinis sp. nov., Knoellia pratensis sp. nov., Knoellia terrae sp. nov. and Knoellia tibetensis sp. nov., four novel UV radiation-resistant actinobacteria isolated from Tibet Autonomous Region, China. Published in IJSEM: doi.org/10.1099/ijsem.… #IJSEM

Rhodotorula silvicola sp. nov., a new yeast species from plant-associated substrates and mushroom. Published Open Access and fee-free in IJSEM using a Publish and Read agreement: doi.org/10.1099/ijsem.… #IJSEM #PublishAndRead
Chlamydia vaughanii sp. nov., a novel Chlamydia isolated from a tropical fish (bushymouth catfish). See more in IJSEM: doi.org/10.1099/ijsem.… #IJSEM

Melissospora conviva gen. nov., sp. nov., a novel actinobacterial genus isolated from beehive through cross-feeding interactions. Published Open Access and fee-free in IJSEM using a Publish and Read agreement: doi.org/10.1099/ijsem.… #IJSEM #PublishAndRead

Clostridium caseinilyticum sp. nov., a close relative of Clostridium tepidum and Clostridium sporogenes, isolated from spoiled cheese and silage. See more in IJSEM: doi.org/10.1099/ijsem.… #IJSEM

Genome-based reclassification of the genus Lactococcus and two novel species Pseudolactococcus yaeyamensis gen. nov., sp. nov. and Lactovum odontotermitis sp. nov. isolated from the gut of termites. Published #OpenAccess and fee-free in #IJSEM using a #PublishAndRead agreement:

Streptomyces sediminimaris sp. nov., a novel actinobacterium with anticancer potential isolated from mangrove sediments. Find out more in #IJSEM: doi.org/10.1099/ijsem.…

Fodinibius alkaliphilus sp. nov., a moderately halophilic and alkaliphilic bacterium isolated from an inland saltern in central Portugal and reclassification of Aliifodinibius salipaludis as Fodinibius salipaludis sp. nov. Discover more in IJSEM: doi.org/10.1099/ijsem.… #IJSEM

Pseudomonas lyxosi sp. nov., Pseudomonas arabinosi sp. nov. and Pseudomonas frigoris sp. nov., isolated from glaciers. Published #OpenAccess and fee-free in #IJSEM using a #PublishAndRead agreement: doi.org/10.1099/ijsem.…

A description of a new species belonging to the genus Hannaella is on the current issue of #IJSEM . This paper results as a collaboration between PYCC and @YGL_NOVAFCT . A special thanks to everyone involved 😊🌷🧫🔬

Amycolatopsis ponsaeliensis sp. nov., a novel endophytic actinobacterium isolated from the root nodules of Alnus glutinosa. Published #OpenAccess and fee-free in #IJSEM using a #PublishAndRead agreement: doi.org/10.1099/ijsem.…

Something went wrong.
Something went wrong.
United States Trends
- 1. Good Monday 27.7K posts
- 2. TOP CALL 3,782 posts
- 3. AI Alert 1,418 posts
- 4. #centralwOrldXmasXFreenBecky 552K posts
- 5. SAROCHA REBECCA DISNEY AT CTW 572K posts
- 6. #BaddiesUSA 66K posts
- 7. #MondayMotivation 7,538 posts
- 8. Market Focus 2,545 posts
- 9. #LingOrmDiorAmbassador 294K posts
- 10. NAMJOON 55.9K posts
- 11. Check Analyze N/A
- 12. Token Signal 1,880 posts
- 13. Rams 30.5K posts
- 14. #LAShortnSweet 24.3K posts
- 15. DOGE 183K posts
- 16. Chip Kelly 9,308 posts
- 17. Vin Diesel 1,571 posts
- 18. Scotty 10.5K posts
- 19. Stacey 23.8K posts
- 20. Gilligan 4,076 posts










